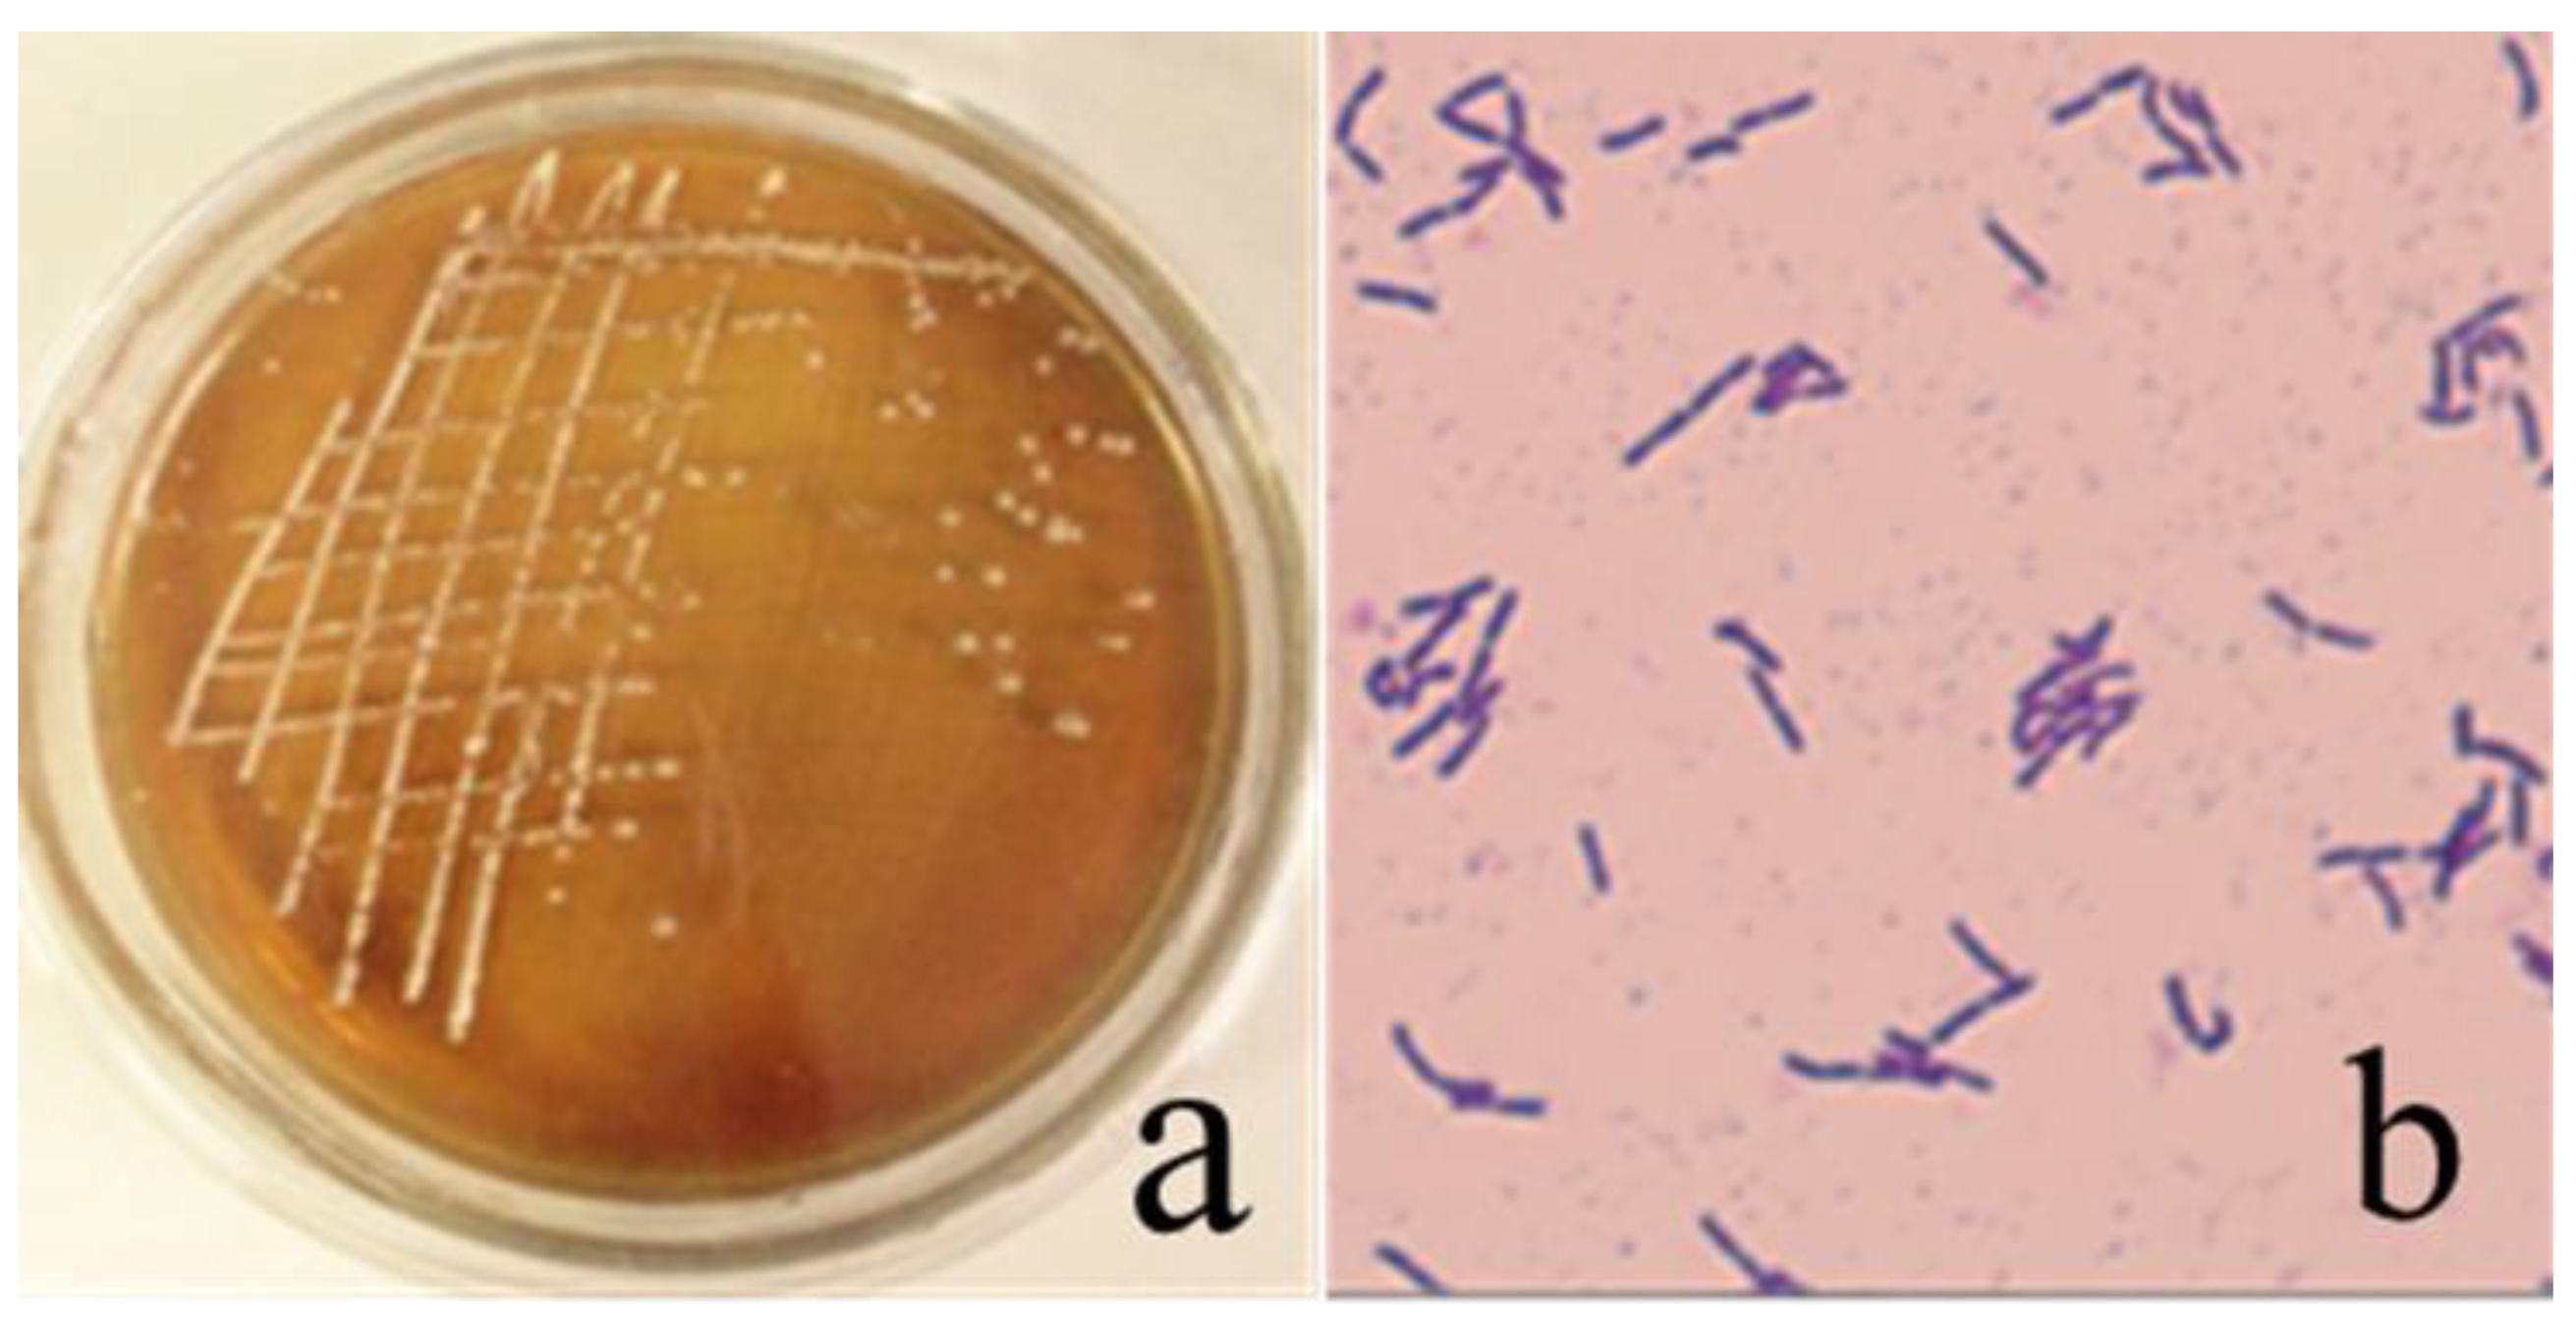
Sustainability 14 09571 g002 550
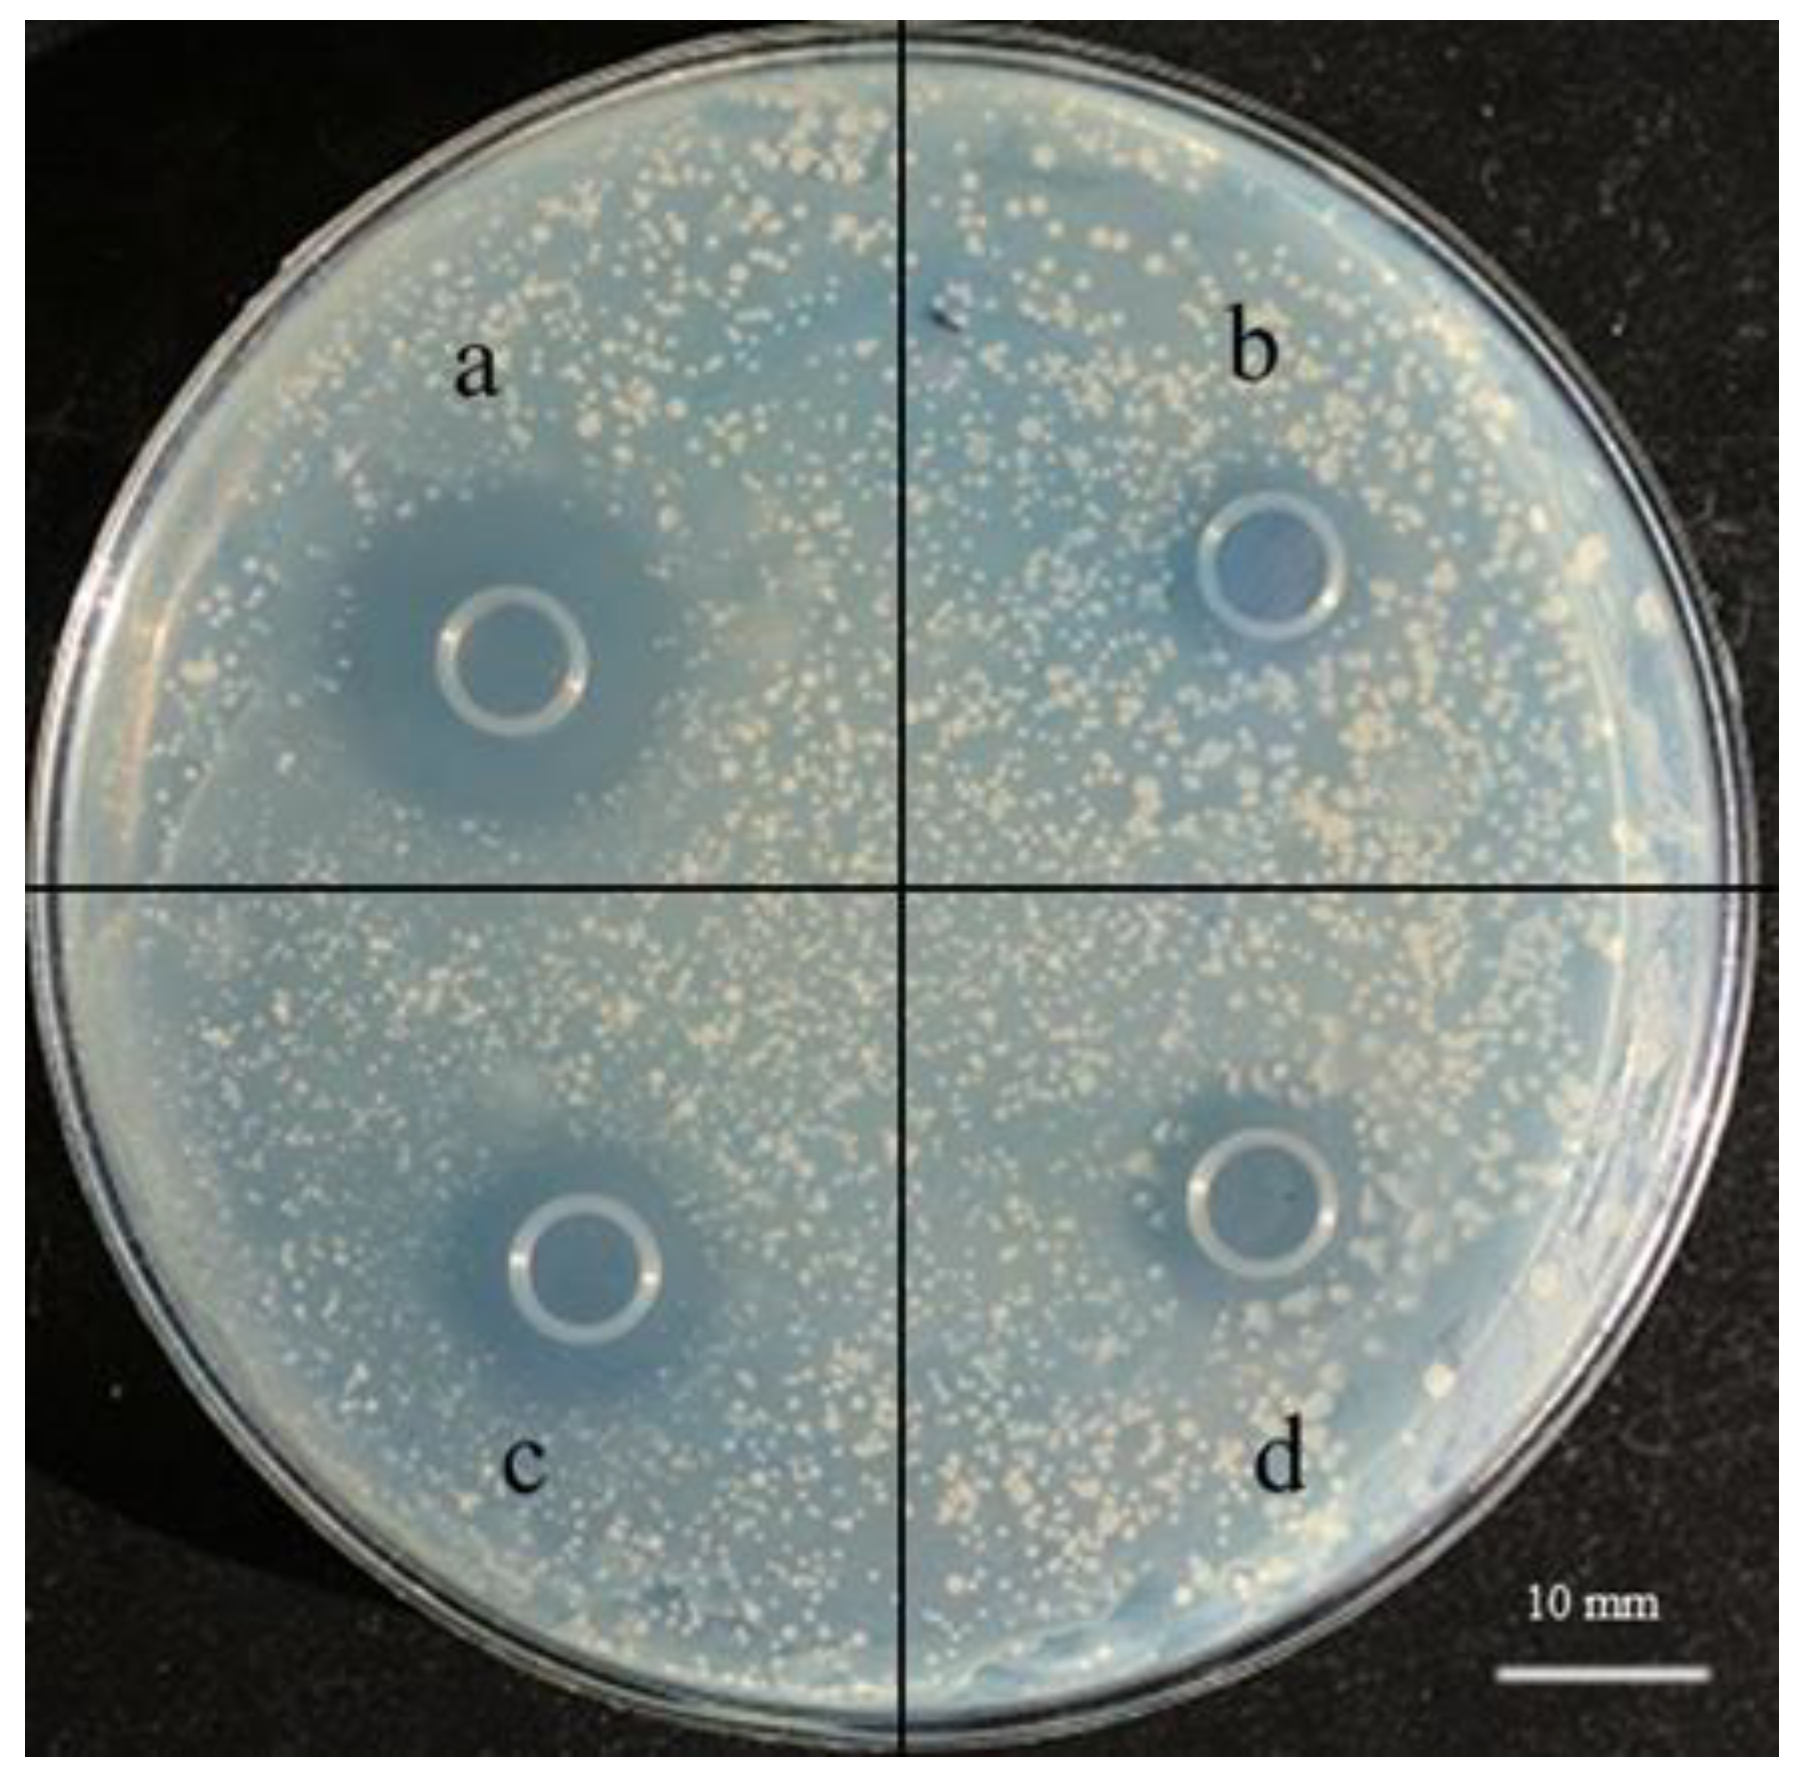
Sustainability 14 09571 g004 550
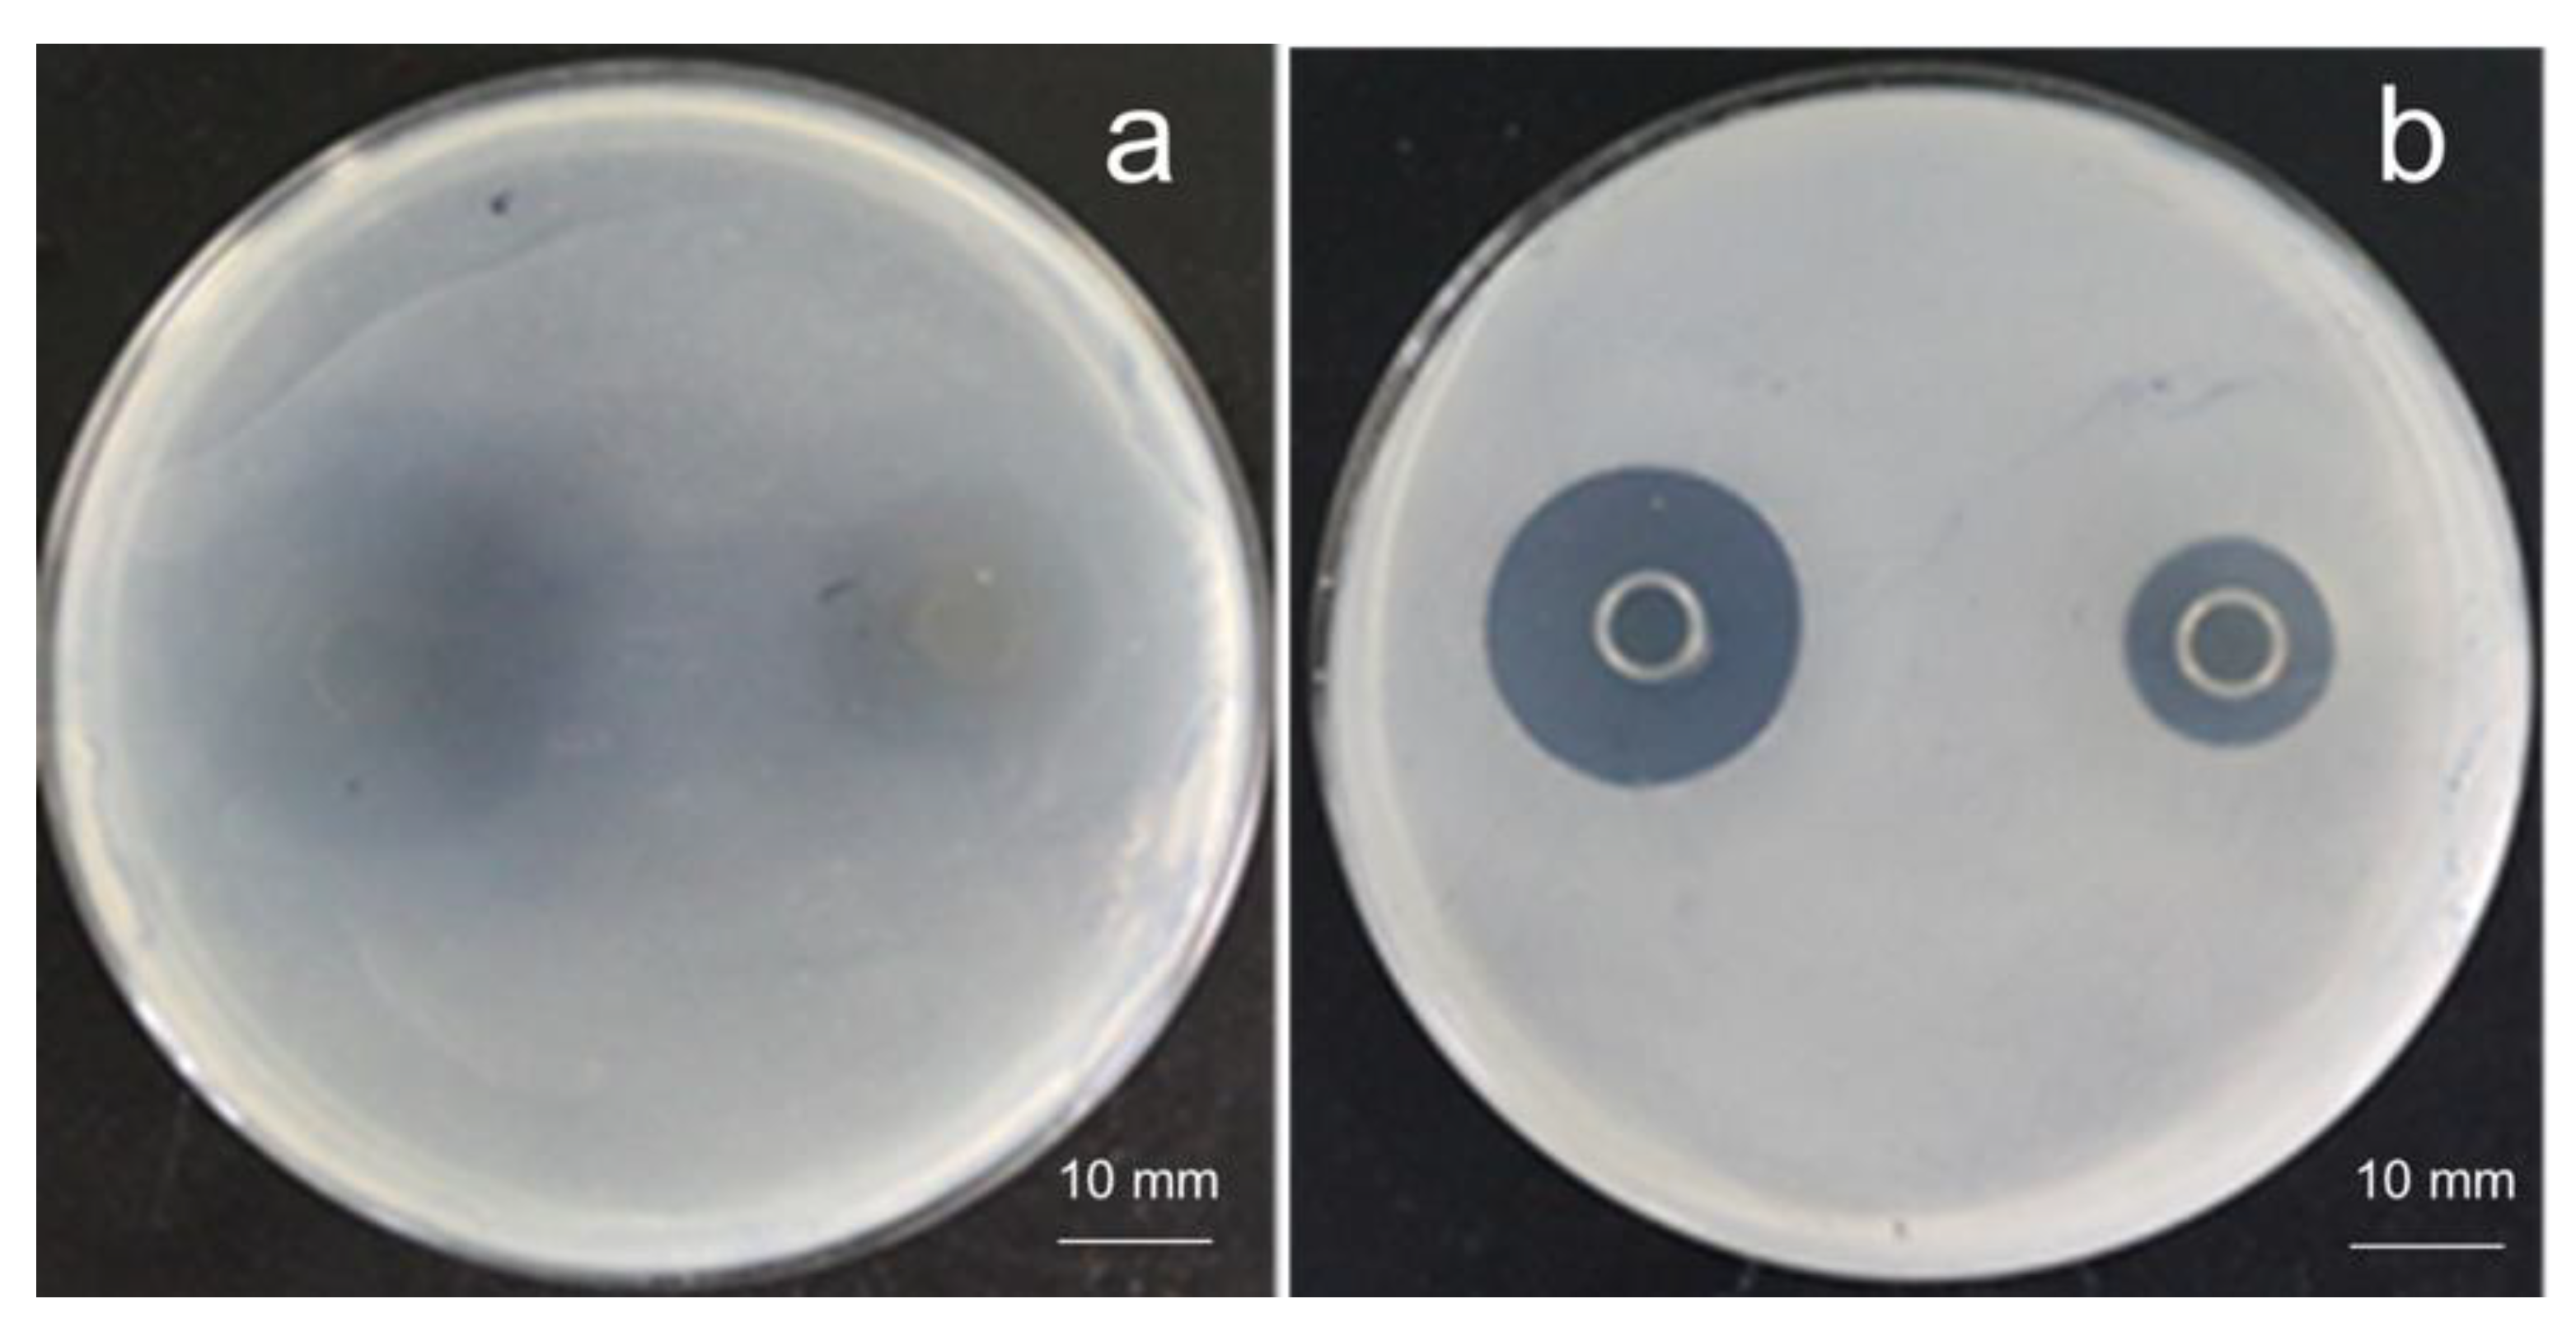
Sustainability 14 09571 g009 550

Bacteriocin from Lacticaseibacillus rhamnosus sp. A5: Isolation, Purification, Characterization, and Antibacterial Evaluation for Sustainable Food Processing
Abstract
:1. Introduction
2. Materials and Methods
2.1. Materials
2.2. Bacterial Strains, Media and Growth Conditions
2.3. Sample Collection, Isolation, and Identification of LAB
2.4. Optimization of Growth Conditions for LAB Fermentation
2.5. LAB Strains and Evaluation of Antibacterial Activity
2.6. Impact of Temperature, pH, and UV Irradiation on Bacteriocins Antibacterial Activity
2.7. Proteinaceous Nature Verification of Bacteriocins
2.8. Extraction and Purification of Bacteriocins
2.9. Data Analysis
3. Results and Discussion
3.1. Isolation and Identification of LAB
3.2. Verification of Bacteriocin Produced by Strain A5
3.3. Strain Growth Curve and Antibacterial Activity
3.4. Sensitivity of Bacteriocin in the Cell-Free Supernatant to pH, Temperature, and UV Irradiation
3.5. Extraction and Purification of Bacteriocins
4. Conclusions
Author Contributions
Funding
Institutional Review Board Statement
Informed Consent Statement
Data Availability Statement
Conflicts of Interest
References
- Braïek, O.B.; Morandi, S.; Cremonesi, P.; Smaoui, S.; Hani, K.; Ghrairi, T. Safety, potential biotechnological and probiotic properties of bacteriocinogenic Enterococcus lactis strains isolated from raw shrimps. Microb. Pathog. 2018, 117, 109–117. [Google Scholar] [CrossRef] [PubMed]
- Meade, E.; Slattery, M.A.; Garvey, M. Bacteriocins, potent antimicrobial peptides and the fight against multi drug resistant species: Resistance is futile? Antibiotics 2020, 9, 32. [Google Scholar] [CrossRef] [PubMed] [Green Version]
- Khodaei, M.; Sh, S.N. Isolation and molecular identification of bacteriocin-producing enterococci with broad antibacterial activity from traditional dairy products in kerman province of Iran. Korean J. Food Sci. Anim. Resour. 2018, 38, 172–179. [Google Scholar]
- Wasfi, R.; El-Rahman, O.A.A.; Mai, M.Z.; Ashour, H.M. Probiotic Lactobacillus sp. inhibit growth, biofilm formation and gene expression of caries-inducing Streptococcus mutans. J. Cell. Mol. Med. 2018, 22, 1972–1983. [Google Scholar] [CrossRef] [Green Version]
- Simons, A.; Alhanout, K.; Duval, R.E. Bacteriocins, antimicrobial peptides from bacterial origin: Overview of their biology and their impact against multidrug-resistant bacteria. Microorganisms 2020, 8, 639. [Google Scholar] [CrossRef]
- Cleveland, J.; Montville, T.J.; Nes, I.F.; Chikindas, M.L. Bacteriocins: Safe, natural antimicrobials for food preservation. Int. J. Food Microbiol. 2001, 71, 1–20. [Google Scholar] [CrossRef]
- Rajoka, M.S.R.; Zhao, H.; Lu, Y.; Lian, Z.; Li, N.; Hussain, N.; Shi, J. Anticancer potential against cervix cancer (HeLa) cell line of probiotic Lactobacillus casei and Lactobacillus paracasei strains isolated from human breast milk. Food Funct. 2018, 9, 2705–2715. [Google Scholar] [CrossRef]
- Rajoka, M.S.R.; Hayat, H.F.; Sarwar, S.; Mehwish, H.M.; Ahmad, F.; Hussain, N.; Shi, J. Isolation and evaluation of probiotic potential of lactic acid bacteria isolated from poultry intestine. Microbiology 2018, 87, 116–126. [Google Scholar] [CrossRef]
- Altay, F.; Karbancıoglu-Güler, F.; Daskaya-Dikmen, C.; Heperkan, D. A review on traditional Turkish fermented non-alcoholic beverages: Microbiota, fermentation process and quality characteristics. Int. J. Food Microbiol. 2013, 67, 44–56. [Google Scholar] [CrossRef] [Green Version]
- Arasu, M.V.; Al-Dhabi, N.A.; Rejiniemon, T.S. Identification and characterization of Lactobacillus brevis P68 with antifungal, antioxidant and probiotic functional properties. Indian J. Microbiol. 2015, 55, 19–28. [Google Scholar] [CrossRef]
- Zhou, F.; Zhao, H.; Bai, F.; Dziugan, P.; Zhang, B. Purification and characterisation of the bacteriocin produced by Lactobacillus plantarum, isolated from chinese pickle. Czech J. Food Sci. 2014, 32, 430–436. [Google Scholar] [CrossRef] [Green Version]
- Karim, N.; Djamel, D.; Ismail, F. Purification of pediocin PA-1 by immunoaffinity chromatography. J. AOAC Int. 2008, 91, 828–832. [Google Scholar]
- Moračanin, S.M.V.; Dukić, D.A.; Memiši, N.R. Bacteriocins produced by lactic acid bacteria—A review. APCBEE Procedia 2012, 2, 50–56. [Google Scholar]
- Zhang, J.; Bilal, M.; Liu, S.; Lu, H.; Luo, H.; Zhao, Y. Isolation, identification and antimicrobial evaluation of bactericides secreting Bacillus subtilis Natto as a biocontrol agent. Processes 2020, 8, 259. [Google Scholar] [CrossRef] [Green Version]
- Elyass, M.E.; Shigidi, M.T.; Attitalla, I.H.; Mahdi, A.A. Characterization and optimization of bacteriocin from Lactobacillus plantarum isolated from fermented beef (Shermout). Open J. Appl. Sci. 2017, 7, 83–97. [Google Scholar] [CrossRef]
- Abbasiliasi, S.; Tan, J.; Tengkuibrahim, T.; Bashokouh, F. Fermentation factors influencing the production of bacteriocins by lactic acid bacteria: A review. RSC Adv. 2017, 7, 29395–29420. [Google Scholar] [CrossRef]
- Altena, K.; Guder, A.; Cramer, C.; Bierbaum, G. Biosynthesis of the lantibiotic mersacidin: Organization of a type B lantibiotic gene cluster. Appl. Environ. Microbiol. 2000, 66, 2565–2571. [Google Scholar] [CrossRef] [Green Version]
- Klaenhammer, T.R. Genetics of bacteriocins produced by lactic acid bacteria. FEMS Microbiol. Rev. 1993, 12, 39–85. [Google Scholar] [CrossRef]
- Gao, Y.; Jia, S.; Gao, Q.; Tan, Z. A novel bacteriocin with a broad inhibitory spectrum produced by Lactobacillus sake C2, isolated from traditional Chinese fermented cabbage. Food Control 2010, 21, 76–81. [Google Scholar] [CrossRef]
- Zhou, B.; Zhang, D. Antibacterial effects of bacteriocins isolated from Lactobacillus rhamnosus (ATCC 53103) in a rabbit model of knee implant infection. Exp. Ther. Med. 2018, 15, 2985–2989. [Google Scholar] [CrossRef] [Green Version]
- Ramya, S.; Mythili, A. Sathiavelu. Recovery of bacteriocin (NISIN) from Lactococcus lactis and testing its ability to increase the shelf life of vegetables (carrot and beans). Res. J. Biol. Sci. 2010, 5, 727–730. [Google Scholar]
- Tiwari, S.K.; Srivastava, S. Purification and characterization of plantaricin LR14: A novel bacteriocin produced by Lactobacillus plantarum LR/14. Appl. Microbiol. Biotechnol. 2008, 79, 759–767. [Google Scholar] [CrossRef]
- Dischinger, J.; Josten, M.; Szekat, C.; Sahl, H.G.; Bierbaum, G. Production of the novel two-peptide lantibiotic lichenicidin by Bacillus licheniformis DSM 13. PLoS ONE 2009, 4, e6788. [Google Scholar] [CrossRef]
- Oscáriz, J.C.; Lasa, I.I.; Pisabarro, A.G. Detection and characterization of cerein 7, a new bacteriocin produced by Bacillus cereus with a broad spectrum of activity. FEMS Microbiol. Lett. 1999, 178, 337–341. [Google Scholar] [CrossRef] [Green Version]
- Lawton, E.M.; Cotter, P.D.; Colin, H.; Paul, R.R. Identification of a novel two-peptide lantibiotic, Haloduracin, produced by the alkaliphile Bacillus halodurans C-125. FEMS Microbiol. Lett. 2007, 267, 64–71. [Google Scholar] [CrossRef]
- Chehimi, S.; Pons, A.M.; Sablé, S.; Hajlaoui, M.R.; Limam, F. Mode of action of thuricin S, a new class IId bacteriocin from Bacillus thuringiensis. Can. J. Microbiol. 2010, 56, 162–167. [Google Scholar] [CrossRef]
- Tahiri, I.; Desbiens, M.; Lacroix, C.; Kheadr, E.; Fliss, I. Growth of Carnobacterium divergens M35 and production of Divergicin M35 in snow crab by-product, a natural-grade medium. LWT Food Sci. Technol. 2009, 42, 624–632. [Google Scholar] [CrossRef]
- Aspri, M.; O’Connor, P.M.; Field, D.; Cotter, P.D.; Papademas, P. Application of bacteriocin-producing Enterococcus faecium isolated from donkey milk, in the bio-control of Listeria monocytogenes in fresh whey cheese. Int. Dairy J. 2017, 73, 1–9. [Google Scholar] [CrossRef]
- Kaur, B.; Kaur, R. Isolation, identification and genetic organization of the ADI operon in Enterococcus faecium GR7. Ann. Microbiol. 2015, 65, 1427–1437. [Google Scholar] [CrossRef]
- Tulini, F.L.; Martinis, E.C.P.D. Improved adsorption-desorption extraction applied to the partial characterization of the antilisterial bacteriocin produced by Carnobacterium maltaromaticum C2. Braz. J. Microbiol. 2010, 41, 493–496. [Google Scholar] [CrossRef] [PubMed] [Green Version]
- Lowry, O.H.; Rosebrough, N.J.; Farr, A.L.; Randall, R.J. Protein measurement with the Folin phenol reagent. J. Biol. Chem. 1951, 193, 265–275. [Google Scholar] [CrossRef]
- Zheng, J.S.; Wittouck, E.; Salvetti, C.M.A.P.; Franz, H.M.B.; Harris, P.; Mattarelli, P.W.; O’Toole, B.; Pot, P.; Vandamme, J.; Walter, K.; et al. A taxonomic note on the genus Lactobacillus: Description of 23 novel genera, emended description of the genus Lactobacillus beijerinck 1901, and union of Lactobacillaceae and Leuconostocaceae. Int. J. Syst. Evol. Microbiol. 2020, 70, 2782–2858. [Google Scholar] [CrossRef]

| Strain No. | Escherichia coli | Bacillus subtilis | Salmonella | Staphylococcus aureus |
|---|---|---|---|---|
| A1 | - | 11.4 ± 0.3 | - | 10.0 ± 0.2 |
| A2 | - | 13.8 ± 0.2 | - | 14.0 ± 0.4 |
| A3 | 15.2 ± 0.2 | 12.5 ± 0.4 | 14.5 ± 0.3 | 13.6 ± 0.3 |
| A4 | - | 12.0 ± 0.2 | - | 13.5 ± 0.2 |
| A5 | 17.3 ± 0.3 | 14.5 ± 0.3 | 16.1 ± 0.1 | 14.2 ± 0.2 |
| Solutions (pH 4.0) | Indicator Bacteria | |
|---|---|---|
| Escherichia coli | Bacillus subtilis | |
| cell-free supernatant | 16.0 ± 0.2 | 15.1 ± 0.2 |
| MRS adjusted by lactic acid | 10.3 ± 0.3 | 8.8 ± 0.2 |
| MRS adjusted by hydrochloric acid | - | - |
| Indicator Bacteria | Treated at 80 °C for 10 min | Untreated |
|---|---|---|
| Escherichia coli | 14.8 ± 0.2 | 15.1 ± 0.2 |
| Bacillus subtilis | 15.3 ± 0.1 | 15.5 ± 0.3 |
| Tube No. | Escherichia coli | Bacillus subtilis |
|---|---|---|
| 20 | 8.0 ± 0.2 | 7.0 ± 0.2 |
| 24 | 10.2 ± 0.1 | 9.4 ± 0.2 |
| 28 | 11.3 ± 0.2 | 10.6 ± 0.1 |
| 32 | 14.0 ± 0.3 | 13.4 ± 0.2 |
| 36 | 12.3 ± 0.2 | 11.0 ± 0.3 |
| 40 | 7.8 ± 0.4 | 7.2 ± 0.2 |
Publisher’s Note: MDPI stays neutral with regard to jurisdictional claims in published maps and institutional affiliations. |
© 2022 by the authors. Licensee MDPI, Basel, Switzerland. This article is an open access article distributed under the terms and conditions of the Creative Commons Attribution (CC BY) license (https://creativecommons.org/licenses/by/4.0/).
Share and Cite
Ren, S.; Yuan, X.; Liu, F.; Fang, F.; Iqbal, H.M.N.; Zahran, S.A.; Bilal, M. Bacteriocin from Lacticaseibacillus rhamnosus sp. A5: Isolation, Purification, Characterization, and Antibacterial Evaluation for Sustainable Food Processing. Sustainability 2022, 14, 9571. https://doi.org/10.3390/su14159571
Ren S, Yuan X, Liu F, Fang F, Iqbal HMN, Zahran SA, Bilal M. Bacteriocin from Lacticaseibacillus rhamnosus sp. A5: Isolation, Purification, Characterization, and Antibacterial Evaluation for Sustainable Food Processing. Sustainability. 2022; 14(15):9571. https://doi.org/10.3390/su14159571
Chicago/Turabian StyleRen, Shiying, Xiaoqing Yuan, Fei Liu, Fang Fang, Hafiz M. N. Iqbal, Sara A. Zahran, and Muhammad Bilal. 2022. "Bacteriocin from Lacticaseibacillus rhamnosus sp. A5: Isolation, Purification, Characterization, and Antibacterial Evaluation for Sustainable Food Processing" Sustainability 14, no. 15: 9571. https://doi.org/10.3390/su14159571
APA StyleRen, S., Yuan, X., Liu, F., Fang, F., Iqbal, H. M. N., Zahran, S. A., & Bilal, M. (2022). Bacteriocin from Lacticaseibacillus rhamnosus sp. A5: Isolation, Purification, Characterization, and Antibacterial Evaluation for Sustainable Food Processing. Sustainability, 14(15), 9571. https://doi.org/10.3390/su14159571

